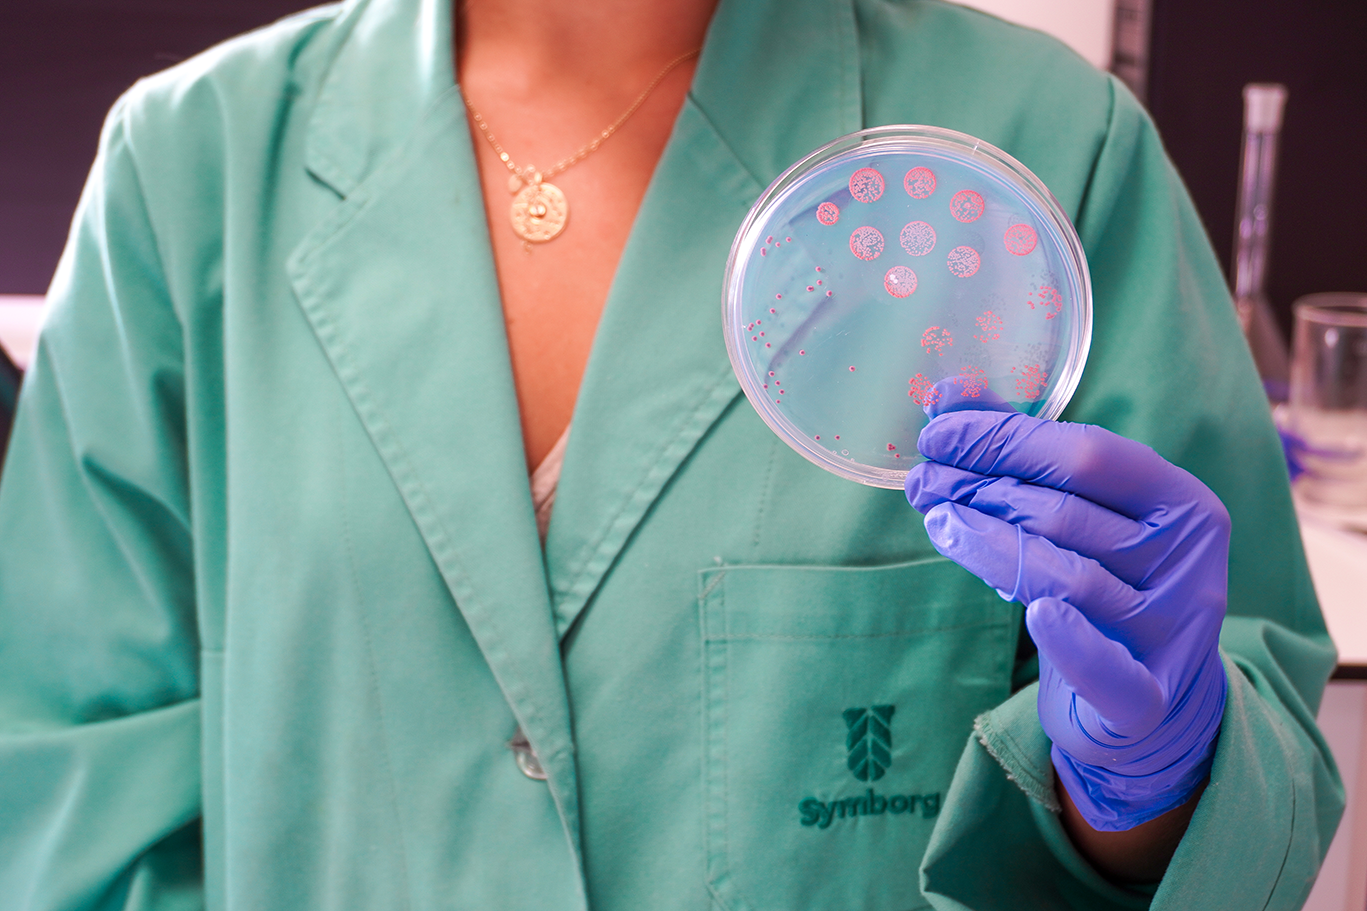

Claves para definir y gestionar eficazmente la estrategia en una empresa agroindustrial
En un entorno competitivo y cambiante que demanda innovación y flexibilidad, es vital elegir la mejor estrategia para lograr los objetivos finales de la empresa. Una herramienta muy útil para visualizar los objetivos, las elecciones estratégicas, y las iniciativas que permiten a las empresas movilizarse de una maniobra a otra, son los tableros estratégicos, representaciones de todas las perspectivas que inciden en su rentabilidad privada, social y medioambiental.
Estrategia, una palabra que a menudo se pronuncia en las reuniones de directorios de las principales empresas agroindustriales del país. “La estrategia no es un proceso discontinuo que se aborda cada tres o cinco años, es un ejercicio permanente, al menos a nivel del directorio”, anota Sebastián Valdés, ingeniero comercial, director de diversas empresas agroindustriales, y con más de 20 años como gerente general y en gerencias de primera línea en vinos, jugos frescos, jugos concentrados, fruta fresca, frutos secos y deshidratados. Fue charlista del Curso de Estrategia de Negocios Agrícolas y Agroindustriales, organizado por Redagrícola, al igual que Juan Francisco Cobo, quien remarca la importancia de tener objetivos finales claros. “Una vez que tenemos definidos los objetivos, podemos abocarnos al desafío de desarrollar el modelo de negocio adecuado para alcanzarlos”, manifiesta Cobo, consultor de estrategia de negocios por más de diez años, en diferentes industrias y organizaciones gubernamentales. Juan Francisco es además autor del libro “Tableros Estratégicos” y co-autor del libro “Estrategia País, de la autoridad al liderazgo”.
¿Qué características debe tener un estratega de los negocios?
Primero, Cobo menciona que es necesario tener una mirada sistémica, que permita comprender en profundidad la forma en que la empresa crea y captura valor. “La mirada sistémica nos muestra todas las variables claves que impactan en la rentabilidad”, apunta Cobo. Por su parte, Valdés sugiere el uso de tableros estratégicos para comprender y explicar la forma en que se relacionan las distintas perspectivas de la empresa para generar impacto en la rentabilidad. “Las iniciativas estratégicas también pueden ser comprendidas o explicadas usando el tablero estratégico”, añade. (ver cuadro 1).
Los objetivos finales tienen a su vez objetivos parciales claves que impactan sobre ellos. Si en una empresa agrícola un objetivo final es obtener una rentabilidad alta sobre la inversión en el tiempo, esta no se podrá obtener sin alcanzar otros objetivos parciales básicos como tener altos ingresos y bajos costos, u otros como buena calidad y condición de la fruta, buena percepción de la marca, mínimo impacto medio ambiental, consumidores finales satisfechos, alta productividad, logística oportuna, uso intensivo de los sistemas de información, mano de obra eficiente, proveedores competitivos de servicios, proveedores competitivos de insumos, uso eficiente de agua, etcétera.
Valdés continúa explicando que, un objetivo parcial como hacer “uso eficiente del agua”, viene acompañado de objetivos tácticos, como contar con un buen sistema de irrigación, un sistema de monitoreo adecuado, y procedimientos de seguimiento y acción. Las elecciones que tome la compañía deben estar en línea con los objetivos tácticos, no una vez, siempre. “La táctica no es un hacer esporádico. La táctica es un método o procedimiento disciplinado para conseguir un objetivo determinado”, comenta Valdés.
GESTIONANDO LA ESTRATEGIA
La gestión de la estrategia es un proceso que debe ser continuo y que apunta a buscar la forma, el cómo, para poder lograr los objetivos más relevantes del negocio en el tiempo. Todo comienza con la identificación del contexto actual y futuro. “Esto que debiese ser la primera parte de la estrategia, muchas veces no se hace”, comenta Valdés. En esta etapa se deben analizar las variables políticas, legales, económicas, medio ambientales, tecnológicas y sociales que pueden impactar los resultados de la empresa.
Otro aspecto importante a tener en cuenta a la hora de gestionar la estrategia es la innovación, el ser capaces de desarrollar nuevos modelos de negocio que sean capaces de adaptarse al contexto actual y futuro. Precisamente, según los expertos, una forma de evitar que la estrategia de negocio sea copiada y mantenga su superioridad en el tiempo es a través de la innovación constante.
¿En qué áreas de negocio se puede innovar? De acuerdo con Valdés, se puede innovar con los actores relevantes al escoger nuevos ‘qué’ y ‘cómo’ para lograr cumplir con ellos. Algunas de las preguntas que puede hacerse una compañía son ¿Cómo lograr mayor sinergia entre los negocios? ¿Cómo lograr menores costos? ¿Cómo proteger el medio ambiente? ¿Cómo tener proveedores más comprometidos? ¿Cómo lograr que el personal esté más comprometido? o ¿Qué distinto le podemos ofrecer a los clientes?
El especialista pone como ejemplo a Camposol, empresa agroindustrial que definió en el 2008 un cambio en su modelo de negocio, y que se usó como caso base del Curso de Estrategia de Negocios Agrícolas y Agroindustriales. Camposol pasó de comercializar sus productos prioritariamente a través de intermediarios, a hacerlo en forma directa, buscando fortalecer la marca e incrementar los márgenes con la integración vertical. “El cambio no se hizo de un día para otro. Primero establecieron una oficina comercial en Rotterdam para acercarse al retail europeo, luego lo hicieron en Estados Unidos. Cada oficina luego se acompañó con centros de distribución”, explica el especialista. Otra de las iniciativas que emprendió la compañía fue diversificar sus productos, privilegiando aquellos que aprovecharan las ventajas climáticas de Perú, en cuanto a ventanas comerciales y productividad. Así iniciaron sus plantaciones de palta, uva de mesa, mandarina y finalmente arándano. Luego Iniciaron su internacionalización de orígenes para complementar su oferta y llenar las ventanas remanentes, estableciéndose en Colombia, Uruguay, México y Chile. Camposol generó en todos estos años una ventaja que pocos reconocen en el mundo agrícola, que es su exitosa apertura al mercado de capitales, lo que le ha permitido acceder y diversificar en fuentes de financiamiento para su crecimiento.

Los expertos sugieren que, ante el desafío de implementar una nueva estrategia, se desarrolle un plan de implementación y gestión del cambio, considerando los posibles obstáculos que se enfrentarán de manera realista. “Es necesario generar una maniobra de gestión del cambio que permita administrar las resistencias a la implementación de la nueva configuración. La estrategia busca cambiar el statu quo y desde ese lado habrá un conjunto de resistencias”, manifiesta Cobo. En la medida que se tenga identificado las posibles resistencias se podrá mitigar el desconocimiento al plan, la subestimación en la implementación y la deficiente gestión del proyecto. “Si no se administran las resistencias voy a fracasar”, añade (ver cuadro 2).
Una forma de gestionar las resistencias es a través del alineamiento estratégico, que hace referencia a cómo las diversas unidades, departamentos y los colaboradores que integran una organización se orientan y actúan en su día a día en torno al plan de desarrollo estratégico, buscando lograr la visión, misión, objetivos y metas de la organización más relevantes en el tiempo.